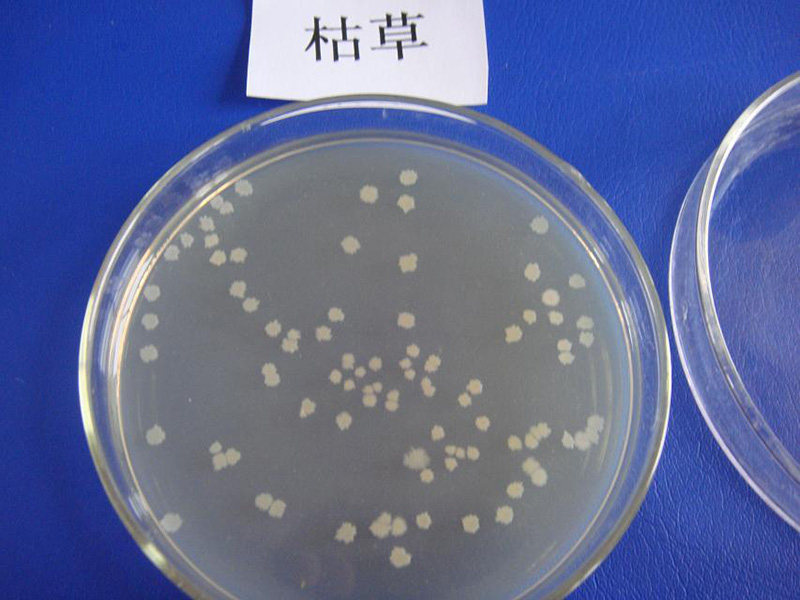

聯系電話:
手機:13939253735
電話:0392-2200221/222/223
E-mail:hnwbsw@163.com
公司地址:河南省鶴壁市淇濱區淇水大道6號觀景大廈

微信掃一掃
手機官網
備案號:豫ICP備15009599號-2
電話:13939253735 Email:hnwbsw@163.com
地址:河南省鶴壁市淇濱區淇水大道6號觀景大廈
其它聯系方式:0392-2200221/222/223
河南省沃寶生物科技有限公司目前已推出產品主要有:有機肥發酵劑、微生物防病蟲害菌劑、微生物飼料發酵劑與添加劑、功能菌等產品。
備案號:豫ICP備15009599號-2 | 網站地圖 XML地圖




